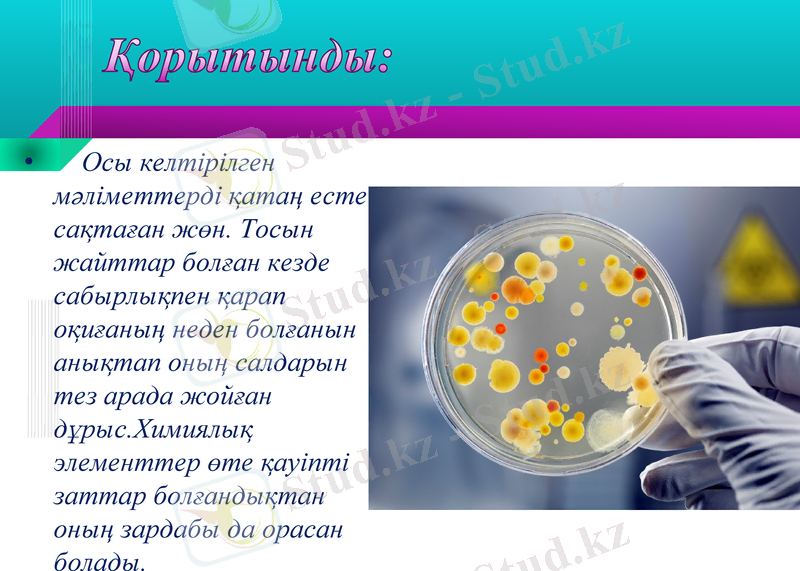
Slide 12

Зертханаларда биологиялық қауіпсіздік: патогендігі I-IV топ микроорганизмдермен жұмыс істеу қағидалары



Тақырыбы: Зертханаларда қолданылатын биологиялық қауіпсіздіктің негіздері. Патогендігі бойынша I-IV топқа жататын микроорганизмдермен жұмыс істеу қауіпсіздігі.
Орындаған:
Тексерген:
«Астана медицина университеті» КеАҚ
«Ш. И. Сарбасов атындағы микробиология және вирусология кафедрасы»
Нұр-Сұлтан, 2020
СӨЖ

Жоспары:
Кіріспе
II. Негізгі бөлім
Микробиологиялық зертхана;
Зертханадағы жұмыс тәртібі;
Зертханадағы жұмыс істеудің қауіпсіздік ережелері;
III. Қорытынды
ІV. Пайдаланылған әдебиеттер тізімі

Микробиологиялық зертхана
Микробиологиялық зертхана арнайы жабдықталған, микробиологиялық бақылау көмегімен инвентарьдың, техникалық құрал - жабдықтар мен аппараттардың, қоғамдық тамақ өнеркәсібінің және тамақ өнімдерін сату жұмысшыларының санитарлық жағдайын тексереді; қоршаған орта обьектілерінің ауа, топырақ, тамақ өнімдерінің микробтармен ластануын зерттейді.

Микробиологиялық зертхана бөлмелері
Зертханалық бөлме
Жуу бөлмесі
Орта пісіру
Зат сақтау
Автоклав
Бокс

Зертханадағы жұмыс тәртібі
Химиялық зертханада жұмыс істегенде мына төмендегі ережелерді қолдану керек:

Зертханада жұмыс істеудің қауіпсіздік ережелері

Микроағзаларды қауыптылығымен байланысты ВОЗ сұрыптауы бойынша төрт топқа бөледі:
1. Аса қауыптылығы жоқ микроағзалар. Күнделік жағдайда адамдардың және жануарлардың ауруларын қоздырмайды (іш таяқша, стафиллококк) .
2. Орташа қауыпты микроағзалар. Адамдардың және жануарлардың ауруларын қоздырады, бірақ күнделік жағдайда аса қауыпты емес (сальмонелла, туберкулез қоздырғыштары, гепатит, менингит вирустері) .
3. Жоғары қауыпты микроағзалар. Осы микроағзалар ауру қоздырады, бірақ бір ағзадан екінші ағзаға берілмейді (бруцеллез қоздырғышы, қан аурулары) .
4. Өте жоғары қауыпты микроағзалар. Эпидемия таратылуға, ағзада күрделі инфекциялар тұдыруға себеп болатын микроағзалар (оба, шешек, аусыл, сібір жарасының қоздырғыштары) .

Микроағзалар топтарға бөлінуімен байланысты зертханаларды келесі дәрежелерге бөледі:

Патогендігі бойынша I-IV топқа жататын микроорганизмдермен жұмыс істеу қауіпсіздігі

Патогендігі бойынша I-IV топқа жататын микроорганизмдермен жұмыс істеу қауіпсіздігі

Патогендігі бойынша I-IV топқа жататын микроорганизмдермен жұмыс істеу қауіпсіздігі
Қорытынды:
Осы келтірілген мәліметтерді қатаң есте сақтаған жөн. Тосын жайттар болған кезде сабырлықпен қарап оқиғаның неден болғанын анықтап оның салдарын тез арада жойған дұрыс. Химиялық элементтер өте қауіпті заттар болғандықтан оның зардабы да орасан болады.

Пайдаланылған әдебиеттер тізімі:
1. http://adilet. zan. kz/kaz/docs/V050003770_
Микробиология: учебник / Под ред. Зверева В. В. . - М. : ГЭОТАР-Медиа, 2015. - 384 c.
Беляев, С. А. Микробиология: Учебное пособие / С. А. Беляев. - СПб. : Лань П, 2016. - 496c.
- Іс жүргізу
- Автоматтандыру, Техника
- Алғашқы әскери дайындық
- Астрономия
- Ауыл шаруашылығы
- Банк ісі
- Бизнесті бағалау
- Биология
- Бухгалтерлік іс
- Валеология
- Ветеринария
- География
- Геология, Геофизика, Геодезия
- Дін
- Ет, сүт, шарап өнімдері
- Жалпы тарих
- Жер кадастрі, Жылжымайтын мүлік
- Журналистика
- Информатика
- Кеден ісі
- Маркетинг
- Математика, Геометрия
- Медицина
- Мемлекеттік басқару
- Менеджмент
- Мұнай, Газ
- Мұрағат ісі
- Мәдениеттану
- ОБЖ (Основы безопасности жизнедеятельности)
- Педагогика
- Полиграфия
- Психология
- Салық
- Саясаттану
- Сақтандыру
- Сертификаттау, стандарттау
- Социология, Демография
- Спорт
- Статистика
- Тілтану, Филология
- Тарихи тұлғалар
- Тау-кен ісі
- Транспорт
- Туризм
- Физика
- Философия
- Халықаралық қатынастар
- Химия
- Экология, Қоршаған ортаны қорғау
- Экономика
- Экономикалық география
- Электротехника
- Қазақстан тарихы
- Қаржы
- Құрылыс
- Құқық, Криминалистика
- Әдебиет
- Өнер, музыка
- Өнеркәсіп, Өндіріс
Қазақ тілінде жазылған рефераттар, курстық жұмыстар, дипломдық жұмыстар бойынша біздің қор #1 болып табылады.



Ақпарат
Қосымша
Email: info@stud.kz